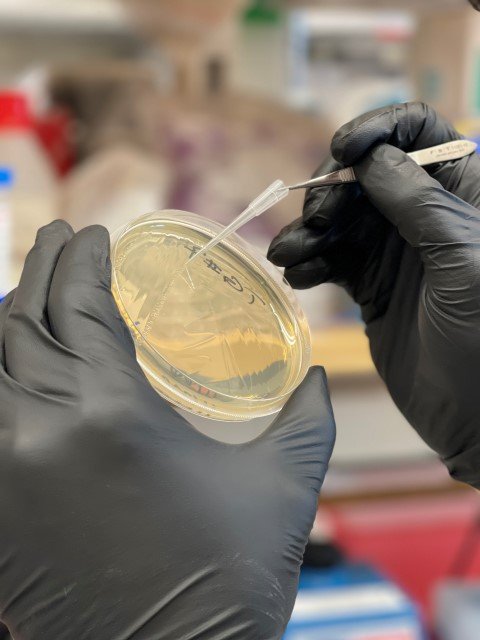

Νευρολογικά προβλήματα, διαταραχές μνήμης και συγκέντρωσης έντονη κόπωση, επίμονος βήχας, πόνος στο στήθος. Αυτά δυστυχώς είναι κάποια από τα συμπτώματα που εμφανίζει ένα σημαντικό ποσοστό ανθρώπων που ασθένησαν από τον Covid-19 πολλούς μήνες μετά τη νόσησή τους.
Πρόκειται για ένα σύνδρομο που ονομάζεται «μακροπρόθεσμο COVID-19» (Long COVID-19) με την επιστήμη να ανακαλύπτει αυτό το διάστημα ότι οι παρενέργειες του ιού μπορούν να γίνουν μακροπρόθεσμες, απρόβλεπτες αλλά και πολύ σοβαρές, επηρεάζοντας όχι μόνο το αναπνευστικό σύστημα, αλλά πολλούς ακόμη τομείς της υγείας, μεταβάλλοντας ταυτόχρονα και αρκετούς βιοδείκτες του ανθρώπινου οργανισμού.
Το iefimerida.gr συνομίλησε με τον Μιχάλη Σπανό, μεταδιδακτορικό ερευνητή στο Κέντρο Καρδιοαγγειακών Ερευνών της Βοστόνης, ο οποίος αυτή την εποχή ηγείται μιας έρευνας στο νοσοκομείο της Μασαχουσέτης -υπό την εποπτεία του πανεπιστημίου του Χάρβαρντ- σχετικά με τις μακροπρόθεσμες συνέπειες του Covid-19 στην ανθρώπινη υγεία. Μέρος της έρευνας αυτή θα δημοσιευτεί σύντομα σε επιστημονικό περιοδικό, ενώ ο Έλληνας επιστήμονας μοιράστηκε ήδη τα βασικά ευρήματα με το iefimerida.gr.
Δείτε τη συνέντευξη του Μιχάλη Σπανού στο Iefimerida:
Όπως διαφαίνεται από τα μέχρι τώρα ευρήματα ο ένας στους δύο από τους ανθρώπους που νόσησαν, εμφανίζει διάφορα συμπτώματα μέχρι και 1,5 χρόνο μετά τη νόσησή τους.
«Οι ασθενείς που έχουν μεγάλο κίνδυνο να εμφανίσουν συμπτώματα επί μακρόν είναι αυτοί που εισήχθησαν στο νοσοκομείο -είτε διασωληνώθηκαν είτε όχι- στο τεράστιο ποσοστό του 78%», μας ενημερώνει ο Μιχάλης Σπανός. Τα συμπτώματα που παρατηρούνται κυρίως είναι διαταραχές συγκεντρώσεως -που εξακριβώνεται και με ειδική εξέταση-, κόπωση, χρόνιος βήχας και έντονος πόνος στο στήθος.

Τα νέα είναι λίγο καλύτερα για όσους νόσησαν ελαφριά, και πάλι όμως όπως φαίνεται πολλοί από αυτούς θα διαπιστώνουν τις συνέπειες της νόσησης για αρκετό καιρό ακόμα στη ζωή τους.
«Ενα μεγάλο ποσοστό έως και 30% όσων απλά πέρασαν Covid θα εκδηλώσει ένα από τα συμπτώματα του long covid. Αναφέρομαι και στους ανθρώπους που μπορεί να πέρασαν τον κορωνοϊό και να μην το κατάλαβαν καν», περιγράφει ο Έλληνας ερευνητής, παραθέτοντας ένα συγκεκριμένο παράδειγμα.
«Υπάρχει περίπτωση που μελετήσαμε ανθρώπου 29 ετών, αθλητή, χωρίς κανένα υποκείμενο νόσημα, ο οποίος πριν από μήνες πέρασε ελαφρά τον Covid-19. Πλέον, παρουσιάζει χρόνιο βήχα σε τέτοιο βαθμό, που τον εμποδίζει στην αθλητική δραστηριότητα».

Σε ερώτημα του iefimerida.gr για το κατά πόσο γνωρίζουμε αν τα συμπτώματα αυτά θα παραμείνουν μόνιμα στον οργανισμό, ο Μιχάλης Σπανός επισημαίνει ότι το ανώτατο μακρό διάστημα που έχει μελετηθεί είναι αυτό των 15 μηνών. «Το 15% όλων των ασθενών που συμμετέχουν στην έρευνά μας έχουν συμπτώματα και μετά από αυτό το διάστημα», μας ενημερώνει, ξεκαθαρίζοντας ότι ακόμα παραμένει άγνωστο αν αυτά θα επιμείνουν και στη συνέχεια.
Πώς είναι δυνατόν όμως μια πνευμονική λοίμωξη, όπως είναι φαινομενικά ο Covid-19, να οδηγεί σε τέτοιο εύρος παρενεργειών στον ανθρώπινο οργανισμό;
Το θέμα βρίσκεται ακόμα υπό εξέταση, όμως για τον Μιχάλη Σπανό το γεγονός αυτό δεν προκαλεί μεγάλη εντύπωση:
«Ο Covid-19 είναι ένας RNA ιός και έχει ορισμένα χαρακτηριστικά τα οποία μέχρι πριν λίγους μήνες δεν τα γνωρίζαμε και δεν σχετίζονται μόνο με την οξεία λοίμωξη. Έχει τη δυνατότητα να ενεργοποιεί ένα πολύ ευρύ σύστημα άμυνας και φλεγμονής στον οργανισμό – μια ανεξέλεγκτη ενεργοποίηση, τη λεγόμενη «καταιγίδα κυτταροκινών». Ενεργοποιεί επίσης τον καταρράκτη πήξεως του αίματος και για αυτό προκαλεί διάφορες θρομβογόνες καταστάσειςόπως πνευμονική εμβολή. Αυτά τα δύο γνωρίσματα πιθανόν κρύβονται πίσω από τις μακροπρόθεσμες συνέπειες».

«Αυτή τη στιγμή ερευνούμε ποιο μέρος της ιικής αυτής λοίμωξης είναι υπεύθυνο για τον μακροπρόθεσμο Covid-19 και στους ασθενείς που δεν έχουν νοσήσει σοβαρά», συμπληρώνει ο επιστήμονας.
Η ουσία αυτών των ερευνών, που βρίσκονται σε πλήρη εξέλιξη και στις οποίες συμμετέχει ενεργά ο Έλληνας ερευνητής, αναμένεται να βοηθήσουν πολύ στη «διαστρωμάτωση του κινδύνου των ασθενών», δηλαδή αρχικά στην αναγνώριση των ασθενών που είναι σε κίνδυνο να εμφανίσουν long COVID-19, στον καθορισμό της πρόγνωσής τους πριν εμφανίσουν τα μακροπρόθεσμα συμπτώματα και τέλος στην αξιολόγηση της ενδεδειγμένης θεραπείας που θα είναι πιο αποτελεσματική για τον εκάστοτε ασθενή.
Εμβόλια και πιθανές μακροπρόθεσμες παρενέργειες
Ρωτήσαμε τον Μιχάλη Σπανό εάν από τη στιγμή που διαφαίνονται μακροπρόθεσμες παρενέργειες από τον Covid-19, το ίδιο θα μπορούσε να ισχύει και για τα εμβόλια εναντίον αυτής της λοίμωξης.
«Χωρίς κλινικές έρευνες και αποτελέσματα είναι δύσκολο να αποκλείσουμε οποιαδήποτε πιθανότητα. Όμως, με βάση τα όσα ξέρουμε για τη λειτουργία των mRNA εμβολίων, εγώ προσωπικά δεν μπορώ να φανταστώ ότι υπάρχουν μακροπρόθεσμες παρενέργειες δεδομένου ότι το μόριο mRNA που εισάγεται στον οργανισμό μας έπειτα από τον εμβολιασμό εισχωρεί μεν στα κύτταρα με σκοπό να δώσει τις «οδηγίες» για το πως θα παραχθεί η πρωτεΐνη ακίδα του ιού αλλά έπειτα αποσυντίθεται και καταστρέφεται. Επομένως, δεν βλέπω πώς θα μπορούσε να συμβεί κάτι τέτοιο».

Οι μεταλλάξεις του ιού και πόσο κινδυνεύουμε
Όσο για τις μεταλλάξεις του ιού που παρατηρούνται, αλλά και για το μέλλον της πανδημίας, ο ερευνητής εμφανίζεται πιο αισιόδοξος.
«Αυτό που θα συμβεί είναι η μετάβαση από την πανδημία στην επιδημία και έπειτα τελικά στην ενδημία, δηλαδή σε περιορισμένης έκτασης, εποχιακή και αντιμετωπίσιμη πια διασπορά του ιού. Ο ιός θα συνεχίσει να μεταλλάσσεται διαρκώς, αυτή είναι άλλωστε και η βάση της βιολογικής του εξέλιξης. Το ανοσοποιητικό σύστημα των ανθρώπων σε επίπεδο κοινωνίας όμως θα αναπτύξει τα κατάλληλα αντισώματα -θα επιτευχθεί δηλαδή η λεγόμενη ανοσία της αγέλης . Αυτό που δεν μπορεί να απαντηθεί είναι το «πότε» θα συμβεί αυτό», επισημαίνει ο ερευνητής.
«Τα νέα στελέχη θα γίνονται πιο μεταδοτικά αλλά θα σκοτώνουν πολύ λιγότερο ή ακόμα θα προκαλούν ελάχιστα συμπτώματα. Ήδη θεωρώ ότι έχουν υπάρξει θανατηφόρες μεταλλάξεις, οι οποίες όμως εξαφανίστηκαν αφού σκότωσαν τα θύματά τους», τονίζει.
Και τελικά, «ο Covid-19 θα καταστεί μια ίωση που κάθε χρόνο θα εμφανίζει διαφορετικά στελέχη, τα οποία θα αναγνωρίζονται και θα πρέπει να δημιουργούνται τα κατάλληλα εμβόλια για αυτά. Στη συνέχεια θα αναγνωριστούν οι ασθενείς υψηλού κινδύνου, και αυτοί είναι που θα πρέπει να εμβολιάζονται κάθε χρόνο. Είναι κάτι πρωτοφανές αυτό; Όχι, συμβαίνει εδώ και χρόνια με την εποχική γρίπη.
Ανοσία αγέλης μπορούμε και χωρίς εμβόλια, αλλά με πολύ περισσότερους νεκρούς...
Ρωτάμε τέλος τον Μιχάλη Σπανό για το κατά πόσο θεωρεί ότι το εκτενές πρόγραμμα εμβολιασμού είναι απαραίτητο ώστε κάποια στιγμή να καταστεί ο κορωνοϊός μια αμελητέα για τη λειτουργία της κοινωνίας μας ίωση.
«Η ανοσία της αγέλης μπορεί να επιτευχθεί και χωρίς τα εμβόλια. Αλλά με πολύ περισσότερα θύματα. Με πολλούς νεκρούς δηλαδή που δεν χρειαζόταν να χάσουν τη ζωή τους για να το επιτύχουμε αυτό»…